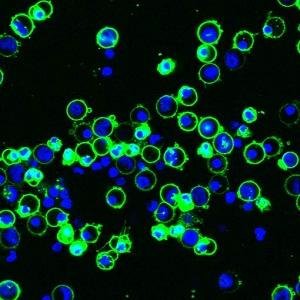
Heather Wilson

Heather Wilson
93 posts

Heather Wilson
@HeatherWilson73
Inflammation and Cardiovascular Biology at the University of Sheffield.




Co-transcriptional Loading of RNA Export Factors Shapes the Human Transcriptome cell.com/molecular-cell…





New feature on the TRAIN website: "20 Questions in 60 Seconds". First up @Laumcampesino and @HeatherWilson73 train-itn.eu/index.php/20-q…


So @theresa_may won her vote against #Brexit rebels tonight in part by deceiving a new mum with a tiny baby? @joswinson had stayed away as she’d been assured she was ‘paired’ or told a Tory wouldn’t vote to cancel her out. This is outrageous. And from @BrandonLewis, TORY CHAIRMAN



David Randall from @ShefUni_IICD is live on @bbcr4today explaining how virtual colonoscopy technology developed in Sheffield could help clinicians to detect abnormalities in the digestive system. #r4today Listen live: bbc.co.uk/programmes/b00…